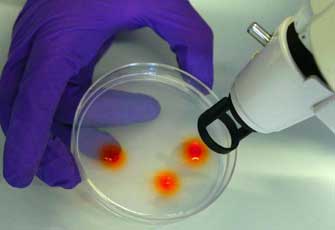
Κάθε άνθρωπος είναι γενετικά πιο μοναδικός από ό,τι πίστευαν οι επιστήμονες

Κάθε άνθρωπος είναι γενετικά πιο μοναδικός από ό,τι πίστευαν οι επιστήμονες
Νέα Υόρκη: Μια νέα αμερικανική έρευνα, έρχεται να δείξει ότι κάθε άνθρωπος είναι, από γονιδιακή άποψη, πιο μοναδικός από ό,τι θεωρούσαν μέχρι σήμερα οι επιστήμονες, κι ενώ φέτος (στις 26 Ιουνίου) συμπληρώνονται δέκα χρόνια από την ανάγνωση του ανθρωπίνου γονιδιώματος.

Αριθμός Πιστοποίησης Μ.Η.Τ.232442
Αριθμός Πιστοποίησης Μ.Η.Τ.232442